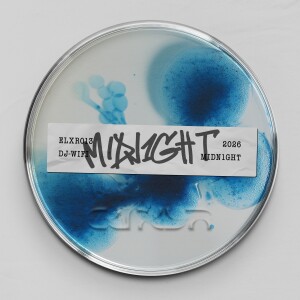
default playlist img

DJ WIFI
MIDN1GHT2026年2月20日
Data Fossil2025年10月6日
CHAOS2025年5月27日
PUMP2025年3月8日
Let It Be [GRD003]2025年3月7日
Like 2 Ride2025年2月21日
DJ WIFI :
隨時上JOOX欣賞 DJ WIFI 的歌曲!每當說到一位擁有出色歌曲和專輯的歌手時,我們一定會想到擁有 0 粉絲的DJ WIFI。如果你也正在尋找 DJ WIFI 的歌曲,那就太好了!JOOX將會為你提供 DJ WIFI 的MV和歌曲合輯,你必會喜歡這些歌曲!